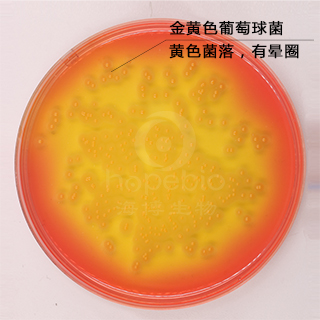
甘露醇卵黄培养基基础

万千商家帮你免费找货
0 人在求购买到急需产品
- 详细信息
- 技术资料
- 英文名:
Egg-Yolk Mannitol Salt agar Base
- 保质期:
3年
- 供应商:
青岛海博生物
- 规格:
250g
用途:用于分离培养病原性金黄色葡萄球菌。
添加剂:每瓶需配套添加 6盒 HB8295 50%卵黄乳液 使用。
用法:
称取本品112.5g ,加热溶解于 1000ml 蒸馏水中,煮沸 1 分钟,121℃高压灭菌15 分钟,冷却至 45-50℃时,无菌操作加入 50% 卵黄乳液 30ml,摇匀,倾入无菌平皿。
不同细菌在甘露醇卵黄培养基上的生长特征
甘露醇卵黄培养基(Japan)微生物灵敏度试验:
按标签用法制备培养基,接种以下质控菌株,放置36±1℃需氧培养24-48小时。
注:回收率计算时,用TSA琼脂做对照培养基。

甘露醇卵黄培养基基础原理和使用方法 http://www.hopebiol.com/asphtml/refere10593.htm
添加剂:每瓶需配套添加 6盒 HB8295 50%卵黄乳液 使用。
用法:
称取本品112.5g ,加热溶解于 1000ml 蒸馏水中,煮沸 1 分钟,121℃高压灭菌15 分钟,冷却至 45-50℃时,无菌操作加入 50% 卵黄乳液 30ml,摇匀,倾入无菌平皿。
不同细菌在甘露醇卵黄培养基上的生长特征
![]() |
![]() |
甘露醇卵黄培养基(Japan)微生物灵敏度试验:
按标签用法制备培养基,接种以下质控菌株,放置36±1℃需氧培养24-48小时。
注:回收率计算时,用TSA琼脂做对照培养基。

甘露醇卵黄培养基基础原理和使用方法 http://www.hopebiol.com/asphtml/refere10593.htm
风险提示:丁香通仅作为第三方平台,为商家信息发布提供平台空间。用户咨询产品时请注意保护个人信息及财产安全,合理判断,谨慎选购商品,商家和用户对交易行为负责。对于医疗器械类产品,请先查证核实企业经营资质和医疗器械产品注册证情况。
技术资料暂无技术资料 索取技术资料
甘露醇卵黄培养基基础
¥190